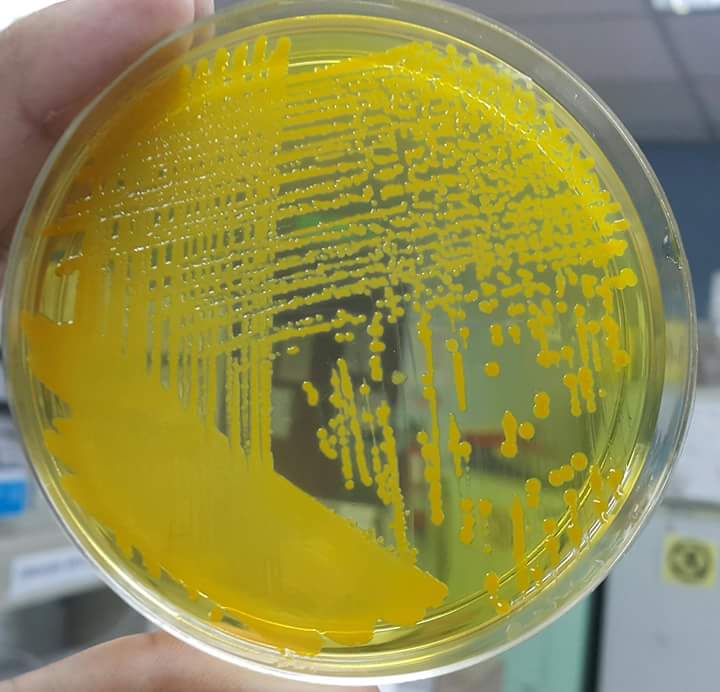
pgbact's tweet image. Vibrio cholerae on TCBS

Peter Pedzisai Gumbo
@pgbact
Bacteriology specialist with interest in public health.
You might like
"To say something in a complicated way is very easy. But to find a way to say it simply—that takes a lot of work." econ.st/2ifskvQ

4 years on, #Anticorruption campaign changes life of civil servants and ordinary Chinese xhne.ws/dALxg

People who do things without being told to do them have the greatest chance at success.

#DecemberAdvice: 1. Don't overspend, January is the longest month 💰 2. Don't drink and drive- value your life and others 🚗 3. Play safe 🍆🍑
Popular read: Implementing Your Business Model With the Galbraith Star Model buff.ly/2f7fuPF

“Future belongs to small populations who build empires of the #mind & ignore the option of exploiting natural resources."-Juan Enriquez.
The secret to success is doing the stuff other people won't do & doing it for a really long time. - John Jantsch #quote
United States Trends
- 1. Wemby N/A
- 2. Rio Rico N/A
- 3. Pacers N/A
- 4. Nancy Guthrie N/A
- 5. #OlandriaxYSLBeauty N/A
- 6. #WWENXT N/A
- 7. Purdue N/A
- 8. Victor Wembanyama N/A
- 9. Tucson N/A
- 10. #LoveOthers N/A
- 11. Wisconsin N/A
- 12. Tumbler Ridge N/A
- 13. Iowa State N/A
- 14. Carlos Palazuelos N/A
- 15. Nebraska N/A
- 16. Zaria N/A
- 17. British Columbia N/A
- 18. Ty Lue N/A
- 19. Real ID N/A
- 20. Blackwell N/A
Something went wrong.
Something went wrong.